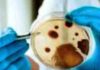
Black fungus cases rise in Andhra Pradesh

Tag: Ram Nath Kovind
Jagan Reddy govt borrowed left and right, Andhra is bankrupt: Chandrababu...
Vijayawada, October 26, 2021: Bogged down by the hostile politics from the state’s ruling YSR Congress Party, Telugu Desam Party (TDP) chief and former...